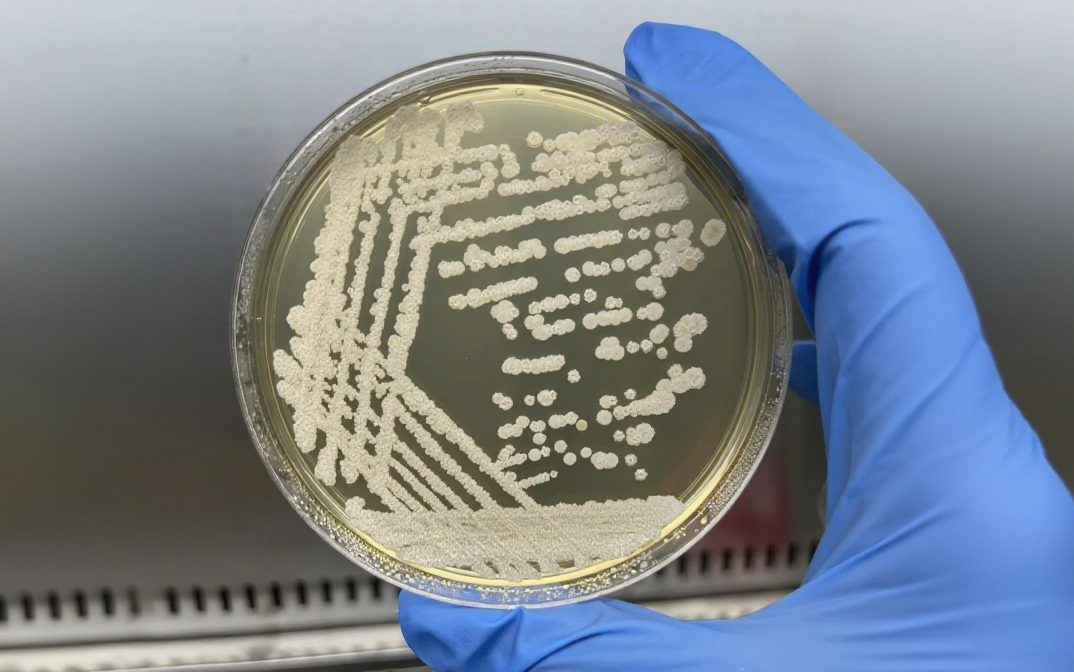
图片

在微生态领域,功能性菌株是决定产品效能与商业价值的核心要素,其功能靶向性、代谢活性及环境耐受性,直接主导产品的市场竞争力。宝来利来依托15万株级功能性菌种资源库,基于微生物学、分子生物学及发酵工程原理,构建起功能性菌株高效筛选、定向优化与全流程质控的核心技术壁垒,成功实现功能性菌株在多场景的产业化落地与价值转化。
功能性菌株的研发始于高质量菌株资源的获取与科学筛选体系的建立,二者共同构成研发链路的基础支撑,可有效规避传统筛选的随机性与低效性。

采用“原生分离+合规引进”构建多元化资源库:联合科研院所、高校等定向采集传统发酵食品、健康肠道菌群及极端环境样本,分离具天然适应性的原生菌株;通过ATCC、CGMCC等机构引进模式菌株,构建15万株功能性菌种资源库,覆盖肠道调节、土壤改良、植物促生抗逆等方向,形成结构化资源储备。
以益生菌为例,先经pH2.0-3.0胃酸、0.3%-0.5%胆盐耐受性初筛,保留存活率>85%菌株;再通过高通量筛选平台,结合HPLC及ELISA技术,快速定量分析功能性代谢产物;最终经16S rRNA基因测序与PCR技术验证,明确菌种分类与功能基因。该体系将筛选周期从3-6个月缩至45天,优于行业平均水平。
定向优化技术:
基于内部改造与外部驯化两大路径
菌株优化以“功能强化”为核心,通过内部分子改造与外部工艺调控的创新路径,实现菌株功能的精准提升与工业化生产的高效适配。
依托合成生物学与基因编辑技术,对菌株进行系统性内部改造,构建具有自主知识产权的益生菌“细胞工厂”。

基因功能强化:通过启动子优化、质粒过表达与基因组整合等手段进行基因功能强化,成功实现代谢产物合成效率的显著提升:乳酸杆菌的抗菌肽表达量提升超3倍,抑菌圈扩大8毫米;芽孢杆菌的蛋白酶酶活提升1400U/mL,增幅达216%。
代谢网络重塑:采用CRISPR-Cas9介导的精确编辑技术,敲除竞争途径关键基因并引入外源高活性酶基因,成功将解淀粉芽孢杆菌的β-葡聚糖酶比酶活提升800U/mg,实现代谢通量定向重排,并使菌株胞外多糖产量提升2.1倍。
通过建立多级自适应驯化体系,实现菌株表型的持续进化。
高耐受性驯化:采用梯度压力筛选策略(pH 2.0-8.0、胆盐0.3%-0.5%、温度15-50℃),使植物乳杆菌的胃酸存活率提升22%,胆盐耐受浓度提升0.8%,肠液定植能力提升4.7倍。
底物适应性进化:通过连续传代培养与动态培养基切换,成功选育出能高效利用豆粕、麸皮等农业副产物的芽孢杆菌新菌株,发酵效价提升156%,在以豆粕为主要氮源的培养基中,菌体得率提升26%。
智能连续进化系统:可实时监测培养参数与反馈调控,将性状改良周期缩短3-5个月,单位容积产能平均提升3.2倍。
基于ISO22000与GMP规范,公司建立“筛选-优化-生产-出厂”全流程质控体系,实现指标量化追溯。
16S rRNA测序与MALDI-TOF MS双重鉴定菌株,排除有害杂菌。
设置多组重复实验,确保功能指标变异系数<5%。
以“三级保藏+超低温冻干”维持90%以上存活率。
产品出厂按照相关企业标准检测活菌数,杂菌率控制<0.5%。
全生命周期追溯系统为菌株分配唯一标识,记录研发全流程数据,实现质量问题快速定位。
宝来利来始终以“产业需求为导向”,建立“市场调研-技术研发-应用验证-产业化落地”的闭环机制,将经筛选优化与全流程质控的优势菌株,精准转化为多场景适配型产品。
紧扣“减抗替抗、生态养殖”刚需,依托自主选育的高耐受、高活性功能菌株,系统构建出营养、免疫、抗感染、环境四大维度的产品体系。相关解决方案已覆盖全国30余个省份的规模化养殖企业,广泛应用于猪、禽、反刍、水产动物等多种品类。
响应化肥减量与土壤改良政策,开发土壤改良、植物营养、生物防控等菌剂,通过功能菌株改良土壤菌群,使土壤有机质提升15%,作物抗逆性提升30%,产量增幅10%-15%,在粮经作物种植中规模化应用。
聚焦肠道微生物领域,依托高定植率、强活性菌株及前沿菌群代谢调控技术,系统探索肠-脑、肠-肺、肠-眼等多器官间的轴系互作网络,围绕益生营养、免疫调控、代谢调节等方向,开发系列通过功能性食品认证的膳食补充剂,产品覆盖全生命周期健康需求,致力于构建从菌群干预到机体多维度功能支持的健康新路径。
依托4万余株功能性菌株,开创“益生菌+”食品新纪元。针对风味优化与健康需求,以专属优化菌株赋能芦荟π饮品、泰山黑猪肉肠、益生菌高钙豆浆粉等产品,强化益生菌活性与营养保留率,提升风味稳定性,适配多元健康场景。
宝来利来凭借15万株级多元化菌种资源库,通过三级靶向筛选、双路径优化及全流程质控体系,构建起功能性菌株研发的核心技术壁垒。技术成果已深度应用于动物养殖、农业种植、健康消费及食品等多元化场景。未来,宝来利来将持续以技术创新为引擎,深化“产学研用”融合,不断拓展微生态技术的应用边界,为生态农业发展、健康产业升级提供坚实支撑,助力行业迈向精准化、高效化、可持续化的高质量发展新阶段。